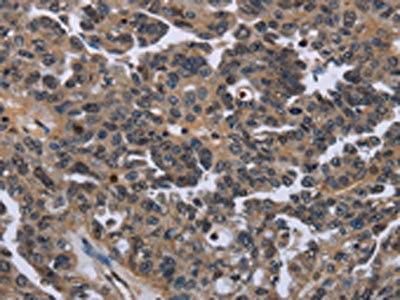

ITGAE Antibody
-
中文名稱:ITGAE兔多克隆抗體
-
貨號:CSB-PA939663
-
規(guī)格:¥1100
-
圖片:
-
The image on the left is immunohistochemistry of paraffin-embedded Human colon cancer tissue using CSB-PA939663(ITGAE Antibody) at dilution 1/50, on the right is treated with fusion protein. (Original magnification: ×200)
-
The image on the left is immunohistochemistry of paraffin-embedded Human ovarian cancer tissue using CSB-PA939663(ITGAE Antibody) at dilution 1/50, on the right is treated with fusion protein. (Original magnification: ×200)
-
Gel: 6%SDS-PAGE, Lysate: 40 μg, Lane: LoVo cells, Primary antibody: CSB-PA939663(ITGAE Antibody) at dilution 1/550, Secondary antibody: Goat anti rabbit IgG at 1/8000 dilution, Exposure time: 3 minutes
-
-
其他:
產(chǎn)品詳情
-
Uniprot No.:
-
基因名:
-
別名:A530055J10 antibody; alpha-E1 antibody; alpha-M290 antibody; aM290 antibody; Antigen CD103 antibody; CD 103 antibody; CD103 antibody; CD103 antigen antibody; HML 1 antigen antibody; HML-1 antigen antibody; HML1 antigen antibody; Human mucosal lymphocyte antigen 1 antibody; Human mucosal lymphocyte antigen 1, alpha subunit antibody; Huminae antibody; Integrin alpha E antibody; Integrin alpha E heavy chain antibody; Integrin alpha E light chain antibody; Integrin alpha E, epithelial-associated antibody; Integrin alpha E1 antibody; Integrin alpha IEL antibody; Integrin alpha M290 antibody; Integrin alpha-E heavy chain antibody; Integrin alpha-IEL antibody; Integrin, alpha E (antigen CD103, human mucosal lymphocyte antigen 1, alpha polypeptide) antibody; Integrin, alpha E antibody; ITAE_HUMAN antibody; Itgae antibody; MGC141996 antibody; MGC183601 antibody; Mucosal lymphocyte 1 antigen antibody; Mucosal lymphocyte antigen 1 antibody
-
宿主:Rabbit
-
反應(yīng)種屬:Human
-
免疫原:Fusion protein of Human ITGAE
-
免疫原種屬:Homo sapiens (Human)
-
標(biāo)記方式:Non-conjugated
-
抗體亞型:IgG
-
純化方式:Antigen affinity purification
-
濃度:It differs from different batches. Please contact us to confirm it.
-
保存緩沖液:Liquid in PBS containing 50% glycerol, 0.5% BSA and 0.02% sodium azide.
-
產(chǎn)品提供形式:Liquid
-
應(yīng)用范圍:ELISA,WB,IHC
-
推薦稀釋比:
Application Recommended Dilution ELISA 1:1000-1:2000 WB 1:200-1:1000 IHC 1:50-1:200 -
Protocols:
-
儲存條件:Upon receipt, store at -20°C or -80°C. Avoid repeated freeze.
-
貨期:Basically, we can dispatch the products out in 1-3 working days after receiving your orders. Delivery time maybe differs from different purchasing way or location, please kindly consult your local distributors for specific delivery time.
-
用途:For Research Use Only. Not for use in diagnostic or therapeutic procedures.
相關(guān)產(chǎn)品
靶點詳情
-
功能:Integrin alpha-E/beta-7 is a receptor for E-cadherin. It mediates adhesion of intra-epithelial T-lymphocytes to epithelial cell monolayers.
-
基因功能參考文獻:
- Co-expression of CD39 and CD103 identifies tumor-reactive CD8 T cells in human solid tumors. PMID: 30006565
- Pxn binding to the CD103 cytoplasmic tail triggers alphaEbeta7 integrin outside-in signaling that promotes CD8(+) T-cell migratory behavior and effector functions. PMID: 29021139
- The CD103+CD4+/CD4+ ratio does not accurately discriminate between sarcoidosis and other causes of lymphocytic alveolitis, neither alone nor in combination with the CD4+/CD8+ ratio, and is not a powerful marker for the diagnosis of sarcoidosis. PMID: 27230039
- CD103 expression in human dendritic cells is regulated differentially by retinoic acid and Toll-like receptor ligands. PMID: 28087652
- detected CD103 tumor cells in 41% (16/39) of lymph node-involved adult T-cell leukemia/lymphoma PMID: 26813744
- Levels of GZMA and ITGAE mRNAs in colon tissues can identify patients with UC who are most likely to benefit from etrolizumab; expression levels decrease with etrolizumab administration in biomarker(high) patients. PMID: 26522261
- PD-1(+)CD103(+) CD8 TIL might regain functional antitumor activity, an effect that potentially could be augmented by immune modulation. PMID: 25957117
- This report highlights the diagnostic difficulties and the need of consensus in categorizing clonal CD103(+) lymphocytosis in patients with refractory celiac disease. PMID: 25637255
- Cell-sorting experiments demonstrated that IDO1 expression is found in a subset of CD1a(+)CD14(-)langerin(+) cells, expressing CD103 PMID: 25584868
- Report CD103 expression occurs most frequently in gastrointestinal T-cell lymphomas. PMID: 25025448
- Tumor-infiltrating lymphocytes expressing the tissue resident memory marker CD103 are associated with increased survival in high-grade serous ovarian cancer. PMID: 24190978
- Using a human CTL system model based on a CD8(+)/CD103(-) T cell clone specific of a lung tumor-associated Ag, we demonstrated that the transcription factors Smad2/3 and NFAT-1 are two critical regulators of this process. PMID: 24477908
- Memory CD103+ CD8 T cells that persist within the brain after an acute infection with vesicular stomatitis virus are bona fide tissue resident memory cells. PMID: 22922816
- Lymphoid tissue (LT)-resident CD8alpha-positive dendritic cells (DCs) and non(LT)-derived CD103-positive DCs express transgenic XCR1 and are characterized by a unique transcriptional fingerprint, irrespective of their tissue of origin. PMID: 21948982
- These findings support the usefulness of CD123 and CD103 to aid in the differential diagnosis of B-cell lymphoproliferative disorders PMID: 21917686
- Studies indicate that the mechanisms that regulate the retention of tissue-resident memory T cells include TGF-beta-mediated induction of CD103 and downregulation of CCR7. PMID: 21739671
- results show that binding of the human alphaE I domain to oral and skin keratinocytes is independent of E-cadherin PMID: 20875079
- has a role in mucosal immunity and graft rejection PMID: 12370249
- Involvement of the adhesive ligand pair CD103-E-cadherin in human thymocyte cell proliferation PMID: 12414996
- Differential up-regulation of CD103 expression on lamina propria lymphocytes in Crohn's disease may indicate differential humoral or cellular regulation in inducing CD103 molecules on lymphocytes in patients with this disease PMID: 14532999
- CD103 promotes destruction of renal allografts by CD8 T cells PMID: 15196058
- Integrin/activation marker CD103 (alphaEbeta7) is expressed on Epstein-Barr virus-specific tonsil-resident (but not peripheral blood mononuclear leukocyte-derived) cytotoxic T lymphocytes. PMID: 16177076
- CD103 expression on dendritic cells influences the balance between effector and regulatory T cell activity in the intestine. PMID: 16216886
- human alloantigen-induced CD103+ CD8+ T cells possess functional features of regulatory T cells PMID: 16920912
- CD8+/CD103+ tumor-reactive T lymphocytes infiltrating epithelial tumors most likely play a major role in antitumor cytotoxic response through alphaEbeta7-E-cadherin interactions. PMID: 17325197
- An investigation to evaluate the diagnostic value of relative number of CD103 expressing CD4(+) T-lymphocytes in the BAL fluid of patients with a variety of interstitial lung diseases, including pulmonary sarcoidosis, is reported. PMID: 18182176
- integrin alpha(E)(CD103)beta(7) is not only involved in epithelial retention, but also in shaping and proper intraepithelial morphogenesis of some leukocytes. PMID: 18492951
- Phenotypic analysis of peripheral blood and decidual CD8+ T cells showed the presence of activated CD8+ T cells as well as a population of CD8+CD103+ T cells in decidual tissue PMID: 19150377
- A higher proportion of CD103+CD4+ T cells and ITGAE -1088 AA genotype might be associated with fibrosis formation in pulmonary sarcoidosis. PMID: 19604725
顯示更多
收起更多
-
亞細胞定位:Membrane; Single-pass type I membrane protein.
-
蛋白家族:Integrin alpha chain family
-
組織特異性:Expressed on a subclass of T-lymphocytes known as intra-epithelial lymphocytes which are located between mucosal epithelial cells.
-
數(shù)據(jù)庫鏈接:
Most popular with customers
-
YWHAB Recombinant Monoclonal Antibody
Applications: ELISA, WB, IHC, IF, FC
Species Reactivity: Human, Mouse, Rat
-
Phospho-YAP1 (S127) Recombinant Monoclonal Antibody
Applications: ELISA, WB, IHC
Species Reactivity: Human
-
-
-
-
-
-